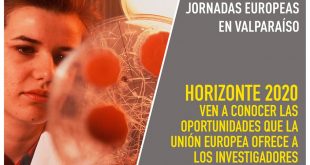

Ambas son componentes de la Comisión Central de Autoevaluación Institucional.
Más informaciónHumedales costeros son clave para medir los efectos del cambio climático
Así lo ratificó el académico de la Facultad de Ingeniería de la Universidad de Playa Ancha, Manuel Contreras López, en seminario internacional de la Agenda Ciudadana COP25.
Más informaciónUniversidad de Playa Ancha se adjudicó dos proyectos Fondeporte
Iniciativas permitirán investigar los efectos de la práctica del surf en escolares de Concón, así como construir y validar un instrumento de medición de hábitos de práctica de actividad física y de deporte para la población escolar chilena.
Más información“Lo más probable es que a mitad de siglo tengamos especies y climas muy distintos”
Entrevista de El Mercurio de Antofagasta al doctor Manuel Contreras, investigador del Centro de Estudios Avanzados (CEA) y académico de la Facultad de Ingeniería.
Más informaciónBases del concurso para proveer cargos académicos en calidad de contrata de la Universidad de Playa Ancha para las facultades de Arte, Ciencias de la Salud y Ciencias Sociales
Las postulaciones serán aceptadas desde el lunes 5 hasta el domingo 11 de agosto.
Más información56 kilómetros cuadrados de la costa de Tarapacá en riesgo por cambio climático
Doctor Manuel Contreras se refirió en La Estrella de Iquique al estudio elaborado por cuatro universidades, el cual afirma que en 30 años podría haber grandes afectaciones por la erosión costera a causa de marejadas.
Más información22 de agosto: Jornadas Europeas para investigadores en Valparaíso
Actividad se efectuará en el Centro de Estudios Avanzados, desde las 11:00 a las 12:30 horas.
Más información30 de agosto: Conferencia «La educación sentimental de las grandes ciudades: desamparo, ‘malandragem’, delincuencia. (Anti) héroes de la literatura brasileña contemporánea»
Conferencia será dictada por el Dr. Horst Nitschack, a las 14:00 horas, en la sala 1 del Centro de Estudios Avanzados Avanzados (Traslaviña 450, Viña del Mar).
Más información30 de agosto: Arqueólogo CEA-UPLA, José Miguel Ramírez, expone en Viernes de Cultura +Ciencia
la actividad se realizará en el Museo Fonck de Viña del Mar, a las 18:00 horas.
Más informaciónInvestigadoras UPLA abren ciclo de charlas de agosto en el Museo Fonck
Se trata de Daiana Nascimento dos Santos, del Centro de Estudios Avanzados, y Ximena Sánchez, académica de la Facultad de Ciencias Sociales, quienes abordarán el tema migratorio.
Más información UPLA.cl
UPLA.cl Noticias de la Universidad de Playa Ancha Dirección General de Comunicaciones
Noticias de la Universidad de Playa Ancha Dirección General de Comunicaciones